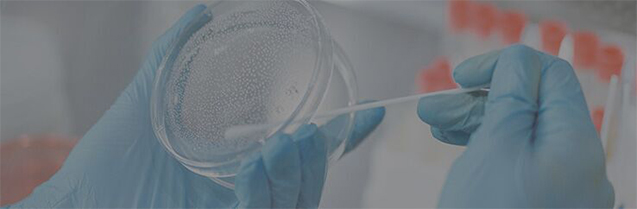

Innowacje
Obecna technologia fermentacji opiera się na mądrości starożytnych. Dlatego używamy wyłącznie bezpiecznych i znanych mikroorganizmów, aby kierunkowo doprowadzić bioaktywność do kontrolowanego i stabilnego etapu, a przede wszystkim poprzez najnowocześniejsze nowoczesne zakłady produkcyjne i zarządzanie.
Innowacja

Dlaczego warto wybrać FermtekTM

10 lat ciągłego doświadczenia w fermentacji

Ogromny bank odmian i zarejestrowanych szczepów

Dwie indywidualne linie produkcyjne do fermentacji i ekstrakcji

Zaawansowane laboratoria wykorzystujące najnowocześniejszy sprzęt

Systemy zapewnienia jakości (takie jak cGMP, HACCP, FSSC22000 itp.)

W pełni kontrolowany proces fermentacji i ekstrakcji
Jak FermtekTMSprawy
Silna platforma badawczo-rozwojowa i wsparcie techniczne

Rosnąca troska o bezpieczeństwo żywności

Wymóg obniżenia kosztów

Zrównoważony rozwój ekologii
Siła B + R
HSF obiera za główny cel model R&D niezależnego R&D, uzupełniony o rozwój współpracy. Utworzyła wspólne laboratorium mikrobiologiczne z Shaanxi Normal University i obecnie ma cztery laboratoria.
1.Laboratoria badań mikrobiologicznych: screening szczepów, mutageneza, inżynieria genetyczna, stymulacja potencjału szczepów.
2. Laboratorium biotransformacji: badanie metabolitów szczepów i aktywności enzymów w celu poprawy wydajności produktu.
3.Laboratorium fermentacji: optymalizacja warunków fermentacji, fermentacja krok po kroku rozszerzanie odpowiedniej produkcji.
4. Laboratorium ekstrakcji i separacji: zbadaj specyficzne warunki ekstrakcji w oparciu o charakterystykę produktu, aby poprawić wydajność i obniżyć koszty.

Zalety HSF FermtekTM

Zaleta pierwsza:
zaawansowana koncepcja zarządzania i nagłośnienie.
Posiadamy międzynarodową, zaawansowaną koncepcję zarządzania warsztatem fermentacyjnym i zbudowaliśmy ścisły system zarządzania jakością (cGMP, ISO22000, ISO9001, Halal, Kosher, SC Certification). Gwarantujemy aseptyczne środowisko, jakość produktów i stabilność pomiędzy partiami produkcyjnymi, aby spełnić wymagania klientów w zakresie bezpieczeństwa produktów i wysokiej jakości.
Zaleta druga:
zaawansowana instalacja urządzeń fermentacyjnych z precyzyjną kontrolą parametrów fermentacji.
HSF jest właścicielem międzynarodowego zaawansowanego sprzętu do fermentacji, sprzętu do filtracji membranowej, sprzętu do liofilizacji i w pełni automatycznego sprzętu sterującego. Dokładnie kontroluj tlen, temperaturę, pH i metodę uzupełniania podczas procesu fermentacji, aby wydobyć maksymalny potencjał szczepu.

Zaleta trzecia:
samodzielnie opracowane opatentowane szczepy i warunki hodowli.
Większość szczepów fermentacyjnych HSF pochodzi z samodzielnie opracowanych szczepów opatentowanych. HSF ma wiodącą w branży wysoką przepustowość i wysokie współczynniki konwersji. Zgodnie z unikalną naturą różnych szczepów, zoptymalizuj warunki fermentacji, opracuj naturalne i niedrogie podłoża hodowlane, obniż koszty i popraw konkurencyjność przemysłu.
Jakość i akredytacja
Zostaliśmy zatwierdzeni w wielu przypadkach audytów na miejscu obiektów i dokumentacji znanych światowych marek. Zarejestrowane SEDEX i Ecovadis z wysokim wynikiem, HSF utrzymuje zdrowy zrównoważony rozwój i odpowiedzialność społeczną, dzięki naszemu zaangażowaniu w wysokie standardy zarządzania, w tym zgodność i bezpieczeństwo, zapewniamy niezrównany poziom pewności naszym klientom.
Gwarantujemy pełną przejrzystość i identyfikowalność każdej wyprodukowanej przez nas partii, zapewniając, że masz wszystko, czego potrzebujesz, aby z pełnym zaufaniem tworzyć obiecujące produkty.

Przygotuj się
Jesteś zainteresowany współpracą z nami w opracowywaniu spersonalizowanych produktów fermentacyjnych? Musisz wypróbować nasze usługi DeePPD™, co oznacza głęboką współpracę produktową, dzielenie się z Tobą możliwościami. Po prostu zostaw nam swoje pomysły i koncepcje!
Skontaktuj się z nami













